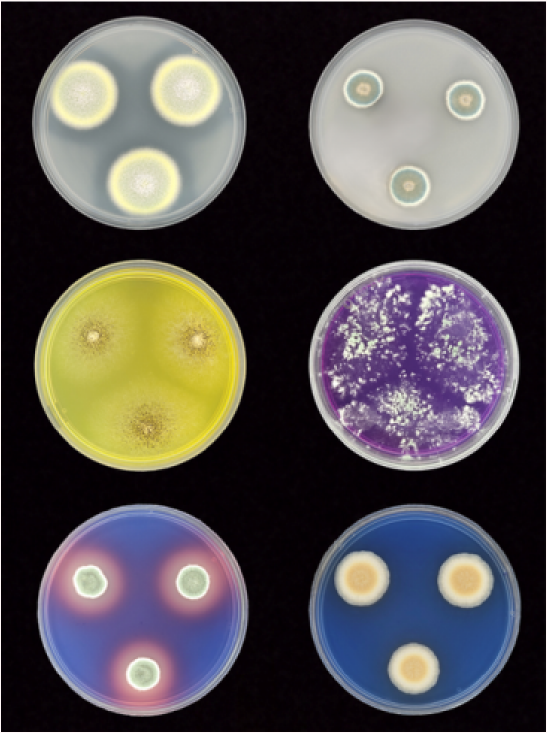
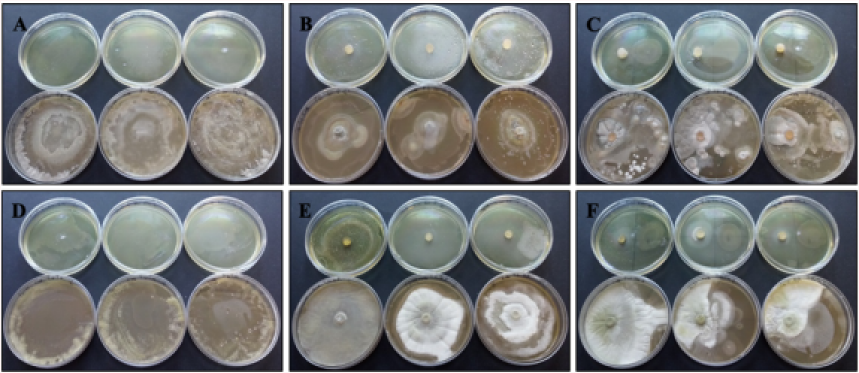

Robotized missions for distributing consortia of microorganisms to bioremediate and biostimulate lands and cultivated areas
The activity described falls within the scope of Spoke 3 of the RAISE project and was designed with the aim of developing and validating an experimental approach based on the use of beneficial microbial consortia applied to the soil, with particular reference to wine-growing contexts. The experiment was conducted in collaboration with industrial and technological partners in the project, including the Azienda Vitivinicola Durin (Fig. 1), owner of the vineyard where the tests were carried out, and Infosolution s.r.l., which provided technological support through a robot dedicated to distributing the fungal solution in the soil. The work is part of a broader sustainable agriculture strategy aimed at enhancing microbial biodiversity as a resource for improving soil quality and crop resilience.

The first phase of the activities involved sampling environmental matrices and isolating microorganisms that could be useful from an agronomic point of view. Soil samples were processed in the laboratory to obtain pure microbial cultures, which were then characterised through morphological observations, growth analyses, and physiological and biochemical tests (Fig. 2). This phase made it possible to identify strains with characteristics compatible with use in agricultural soil and potentially capable of interacting with the rhizosphere of the vine. The selected strains were catalogued and stored, in the Centre of Biological Resources named ColD UNIGE MIRRI-ERIC (founded by PNRR “Strengthening the MIRRI Italian Research Infrastructure for Sustainable Bioscience and Bioeconomy Area ESFRI Health and Food”, granted by the European Commission – NextGenerationEU Code N° IR0000005.it) to be used as a starting point for the subsequent experimental phases.
Subsequently, attention was focused on assessing the compatibility between the various microorganisms selected (Fig. 3). Co-culture tests and combined growth tests were conducted to rule out antagonism and facilitate the identification of stable microbial associations. Based on the results obtained, specific bioconsortia were defined, characterised by complementary functions and good coexistence capacity. This phase proved crucial in ensuring the stability of the consortium and the survival of the microorganisms once applied in field conditions.
The selected bioconsortia were then used to prepare the microbial inoculum (Fig. 4). The inoculum was produced following standardised protocols, with particular attention to concentration, microorganism viability and process reproducibility. The inoculum was formulated in liquid form to allow for uniform application to the soil and to facilitate its distribution in the vineyard. At this stage, the contribution of our partner Infosolution was fundamental, thanks to the provision of a robot dedicated to the controlled distribution of the solution, which allowed us to operate precisely along the rows of the vineyard (Fig. 5).


Subsequently, the experiment continued with monitoring over time to verify the ability of the microorganisms to adapt to the soil environment and persist in the system.
In the months following inoculation, soil samples were taken from the treated areas of the vineyard. From the samples collected, it was possible to isolate the inoculated microbial species again, experimentally confirming their survival and ability to persist in the soil after application. This result is a key element of the experiment, as it demonstrates the effectiveness of the inoculation methods and the stability of the microbial consortia under field conditions.
To date, the experiment is still ongoing, and the observation period is too limited to draw definitive conclusions on the effects of bioconsortia on the development, productivity and physiological status of grapevines. The results obtained so far should therefore be considered preliminary. Further, monitoring and analysis will be necessary in the medium and long term to fully assess the potential benefits of the inoculated microorganisms and to define the real impact of the proposed approach in the wine-growing context.

Product 5.2